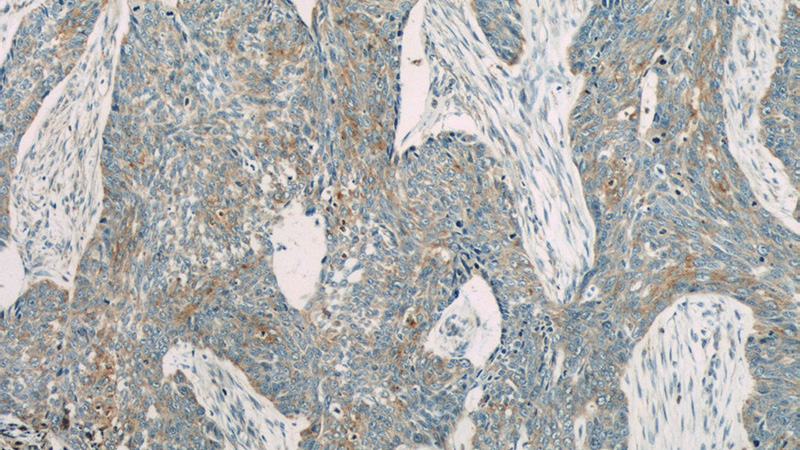
Immunohistochemistry of paraffin-embedded human skin cancer slide using Catalog No:111159(PCDGF,GRN Antibody) at dilution of 1:50
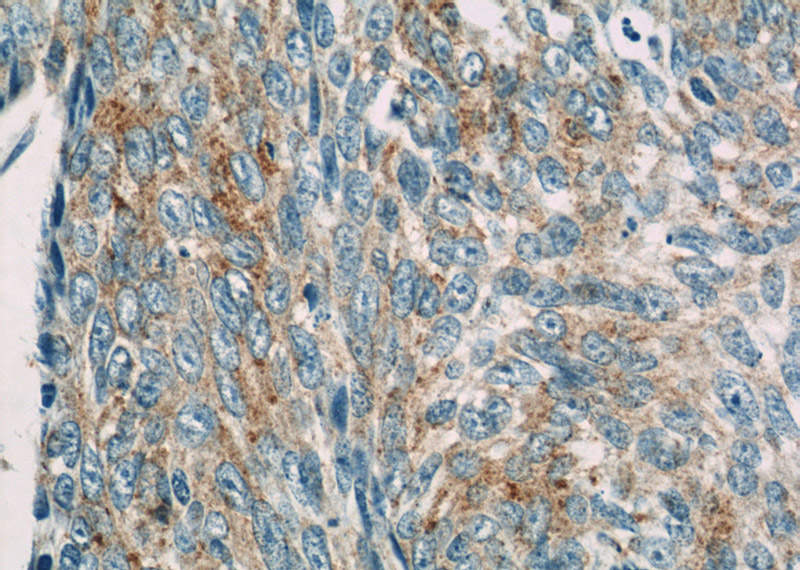
Immunohistochemistry of paraffin-embedded human skin cancer slide using Catalog No:111159(PCDGF,GRN Antibody) at dilution of 1:50

-
Product Name
Granulin antibody
- Documents
-
Description
Granulin Rabbit Polyclonal antibody. Positive IP detected in mouse kidney tissue. Positive WB detected in mouse lung tissue, A431 cells, HEK-293 cells, HeLa cells, mouse heart tissue, mouse kidney tissue, PC-3 cells, rat brain tissue, rat kidney tissue, THP-1 cells, U-937 cells. Positive IHC detected in human skin cancer tissue, human kidney tissue. Observed molecular weight by Western-blot: 68 kDa, 70-88 kDa
-
Tested applications
ELISA, WB, IHC, IP
-
Species reactivity
Human,Mouse,Rat; other species not tested.
-
Alternative names
acrogranin antibody; GEP antibody; GP88 antibody; granulin antibody; Granulin A Granulin 5 antibody; Granulin B Granulin 4 antibody; Granulin C Granulin 6 antibody; Granulin D Granulin 7 antibody; Granulin E antibody; Granulin F Granulin 3 antibody; Granulin G Granulin 2 antibody; Granulins antibody; GRN antibody; PCDGF antibody; PEPI antibody; PGRN antibody; Proepithelin antibody
-
Isotype
Rabbit IgG
-
Preparation
This antibody was obtained by immunization of Granulin recombinant protein (Accession Number: NM_001012479). Purification method: Antigen affinity purified.
-
Clonality
Polyclonal
-
Formulation
PBS with 0.02% sodium azide and 50% glycerol pH 7.3.
-
Storage instructions
Store at -20℃. DO NOT ALIQUOT
-
Applications
Recommended Dilution:
WB: 1:200-1:2000
IP: 1:200-1:2000
IHC: 1:20-1:200
-
Validations

mouse lung tissue were subjected to SDS PAGE followed by western blot with Catalog No:111159(PCDGF,GRN antibody) at dilution of 1:1000

IP Result of anti-PCDGF,GRN (IP:Catalog No:111159, 4ug; Detection:Catalog No:111159 1:800) with mouse kidney tissue lysate 4000ug.
Immunohistochemistry of paraffin-embedded human skin cancer slide using Catalog No:111159(PCDGF,GRN Antibody) at dilution of 1:50
Immunohistochemistry of paraffin-embedded human skin cancer slide using Catalog No:111159(PCDGF,GRN Antibody) at dilution of 1:50
-
Background
GRN, also known as PGRN or PCDGF, is a cysteine-rich protein of 68.5 kDa that is typically secreted into a highly glycosylated 88 kDa form. PGRN is a unique growth factor that plays an important role in cutaneous wound healing. It has an anti-inflammatory effect and promotes cell proliferation. When PCDGF is degraded to several 6–25 kDa fragments, called granulins (GRNs) by neutrophil proteases, a pro-inflammatory reaction occurs. PGRN is widely expressed, particularly in epithelial cells, immune cells, neurons, and chondrocytes. High levels of PGRN expression have been reported in human cancers, and its expression is closely correlated with the development and metastasis of several cancers. The recent discovery that mutations in the gene encoding for pro-granulin (GRN) cause frontotemporal lobar degeneration (FTLD), and other neurodegenerative diseases leading to dementia, has brought renewed interest in progranulin and its functions in the central nervous system.
-
References
- Huang K, Chen A, Zhang X. Progranulin is preferentially expressed in patients with psoriasis vulgaris and protects mice from psoriasis-like skin inflammation. Immunology. 145(2):279-87. 2015.
- Aziz F, Yang X, Wen Q, Yan Q. A method for establishing human primary gastric epithelial cell culture from fresh surgical gastric tissues. Molecular medicine reports. 12(2):2939-44. 2015.
- Loei H, Tan HT, Lim TK. Mining the gastric cancer secretome: identification of GRN as a potential diagnostic marker for early gastric cancer. Journal of proteome research. 11(3):1759-72. 2012.
- Huang K, Huang C, Shan K, Chen J, Li H. Significance of PC cell-derived growth factor and cyclin D1 expression in cutaneous squamous cell carcinoma. Clinical and experimental dermatology. 37(4):411-7. 2012.
- Aziz F, Yang X, Wang X, Yan Q. Anti-LeY antibody enhances therapeutic efficacy of celecoxib against gastric cancer by downregulation of MAPKs/COX-2 signaling pathway: correlation with clinical study. Journal of cancer research and clinical oncology. 141(7):1221-35. 2015.
Related Products / Services
Please note: All products are "FOR RESEARCH USE ONLY AND ARE NOT INTENDED FOR DIAGNOSTIC OR THERAPEUTIC USE"
